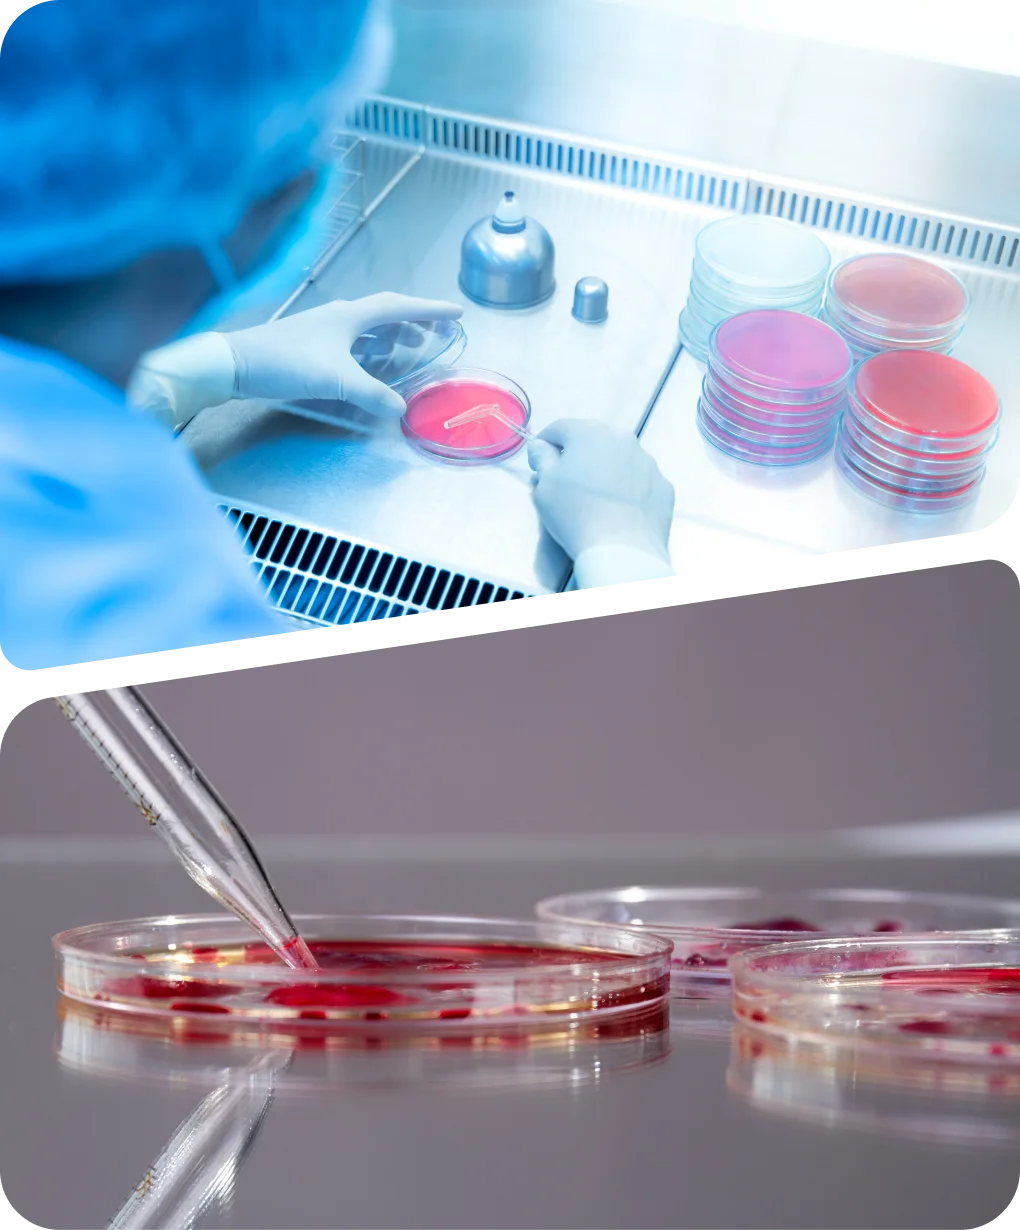
pic- 4

Explant models are biological systems where small pieces of living tissue (explants) are removed from an organism and cultured ex vivo (outside the body) to study cellular behavior, disease, or drug responses in a controlled, near-natural environment that preserves complex cell-matrix interactions. These models are crucial in research, allowing scientists to investigate complex biological processes like bone development, cancer progression, or placental function, often providing more physiological relevance than 2D cell cultures or complex in vivo animal models.